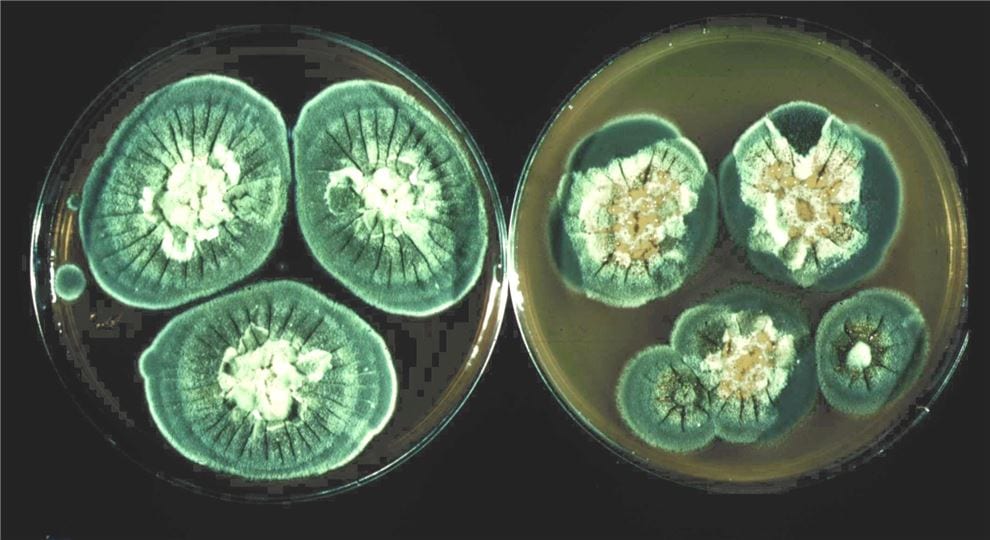

Penicillium fungus grown from original Fleming strain goes on world tour to China and India
Penicillium, a fungus which has been grown from a strain of Sir Alexander Fleming’s original culture maintained by CABI, is currently on a world tour to China and India as part of a ‘Superbugs’ exhibition in conjunction with the Science Museum in London.
SciDev.Net quizzes Congolese health minister on country’s Ebola crisis
SciDev.Net - the world's leading source of reliable and authoritative news, views and analysis about science and technology for global development - has quizzed the Congolese health minister on the country's Ebola crisis which is seeing its efforts to quell the number of cases hampered by violent conflict.
Exploring Fleming’s Penicillium and the potential of microorganisms
On this day in 1906 the biochemist and Nobel laureate Ernst Chain, best known for his work in the synthetic production of penicillin, was born. To mark his birthday, and to highlight a fascinating exhibition on 'Superbugs', the Science Museum has today published a blog and video where CABI's Genetic…
SciDev.Net scoops honour for highlighting neglected tropical diseases
SciDev.Net has picked up a prestigious award from the International Society for Neglected Tropical Diseases (ISNTD) for numerous articles raising the awareness of a range of global health issues including malaria and elephantiasis.
Management of invasive plants could prevent spread of deadly malaria, scientists suggest
CABI scientists have joined an international team of experts who suggest that the large-scale management of a range of some invasive plants could hold the key to reducing the spread of deadly malaria.